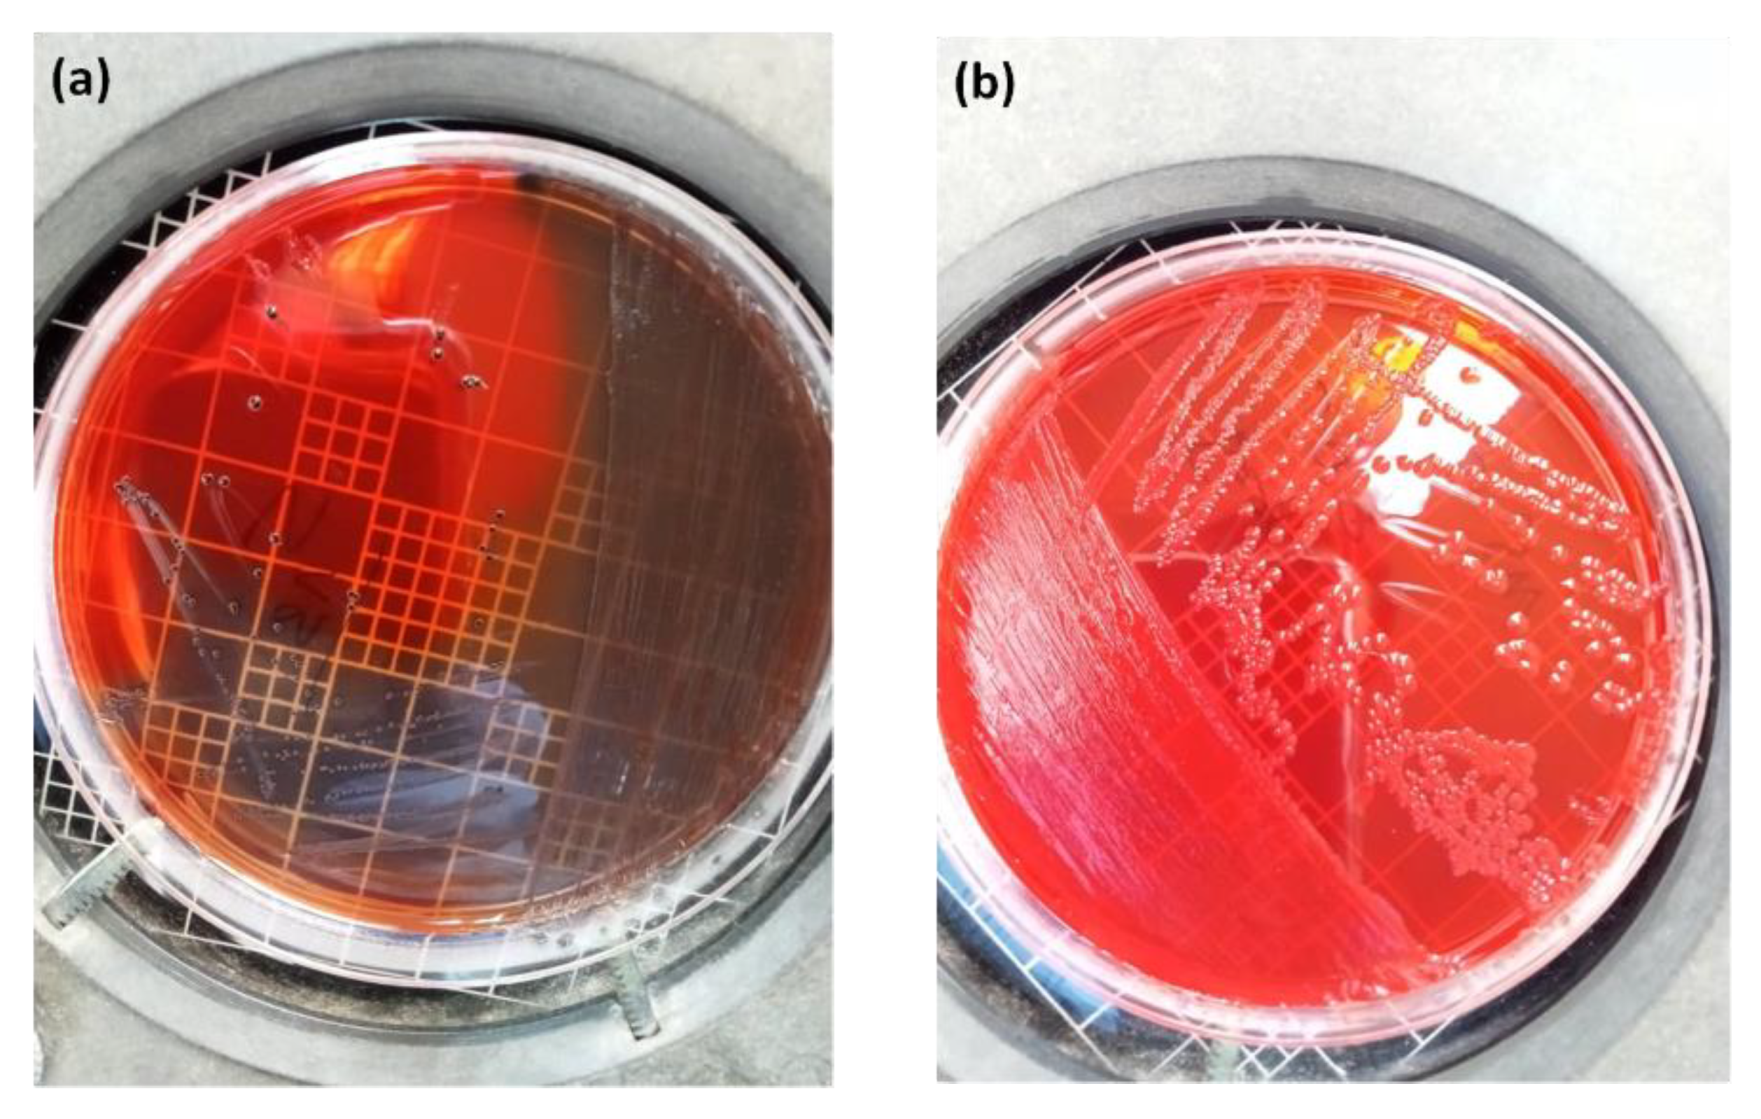
Diagnostics 12 02444 g009

Microbial Diversity and Pathogenic Properties of Microbiota Associated with Aerobic Vaginitis in Women with Recurrent Pregnancy Loss
Abstract
1. Introduction
2. Materials and Methods
2.1. Study Area and Population
2.2. Inclusion and Exclusion Criteria
2.3. Ethical Approval and Sample Collection
2.4. Diagnosis of Bacterial Disorder Using Wet Mount and Gram Stain of Vaginal Smears
2.5. Bacterial Strains and Culture Conditions
2.5.1. Molecular Identification of Cultivated Isolates
2.5.2. Molecular Profiling and Sequencing Analysis
2.5.3. Pathogenic Properties Assays
- Acid-resistance assays
- Antibiotics Susceptibility Test
- Biofilm Formation Assay
2.6. Statistical Analysis
3. Results
3.1. Demographic and Clinical Characteristics
3.2. Prevalence of Aerobic Vaginitis in Study Population
3.3. Microbial Diversity and Molecular Analysis
3.4. Acid Susceptibility Test
3.5. Drug Susceptibility Profiles
3.6. Qualitative and Quantitative Ability for Biofilm Formation
4. Discussion
- Strong points
- Shortcomings
5. Conclusions
Supplementary Materials
Author Contributions
Funding
Institutional Review Board Statement
Informed Consent Statement
Data Availability Statement
Acknowledgments
Conflicts of Interest
References
- Practice Committee of the American Society for Reproductive Medicine. Evaluation and treatment of recurrent pregnancy loss: A committee opinion. Fertil. Steril. 2012, 98, 1103–1111. [Google Scholar] [CrossRef] [PubMed]
- Loss, R.P. Guideline of the European Society of Human Reproduction and Embryology; ESHRE Early Pregnancy Guidline Development Group: Copenhagen, Denmark, 2017; pp. 1–153. [Google Scholar]
- Stephenson, M.; Kutteh, W. Evaluation and management of recurrent early pregnancy loss. Clin. Obstet. Gynecol. 2007, 50, 132–145. [Google Scholar] [CrossRef] [PubMed]
- Macklon, N.S.; Geraedts, J.P.; Fauser, B.C. Conception to ongoing pregnancy: The ‘black box’ of early pregnancy loss. Hum. Reprod. Update 2002, 8, 333–343. [Google Scholar] [CrossRef] [PubMed]
- Dimitriadis, E.; Menkhorst, E.; Saito, S.; Kutteh, W.H.; Brosens, J.J. Recurrent pregnancy loss. Nat. Rev. Dis. Prim. 2020, 6, 98. [Google Scholar] [CrossRef] [PubMed]
- Balkus, J.; Agnew, K.; Lawler, R.; Mitchell, C.; Hitti, J. Effects of pregnancy and bacterial vaginosis on proinflammatory cytokine and secretory leukocyte protease inhibitor concentrations in vaginal secretions. J. Pregnancy 2010, 2010, 385981. [Google Scholar] [CrossRef]
- Liu, Y.; Wong, K.K.; Ko, E.Y.; Chen, X.; Huang, J.; Tsui, S.K.; Li, T.C.; Chim, S.S. Systematic Comparison of Bacterial Colonization of Endometrial Tissue and Fluid Samples in Recurrent Miscarriage Patients: Implications for Future Endometrial Microbiome Studies. Clin. Chem. 2018, 64, 1743–1752. [Google Scholar] [CrossRef]
- Smith, S.B.; Ravel, J. The vaginal microbiota, host defence and reproductive physiology. J. Physiol. 2017, 595, 451–463. [Google Scholar] [CrossRef]
- Donders, G. Diagnosis and management of bacterial vaginosis and other types of abnormal vaginal bacterial flora: A review. Obstet. Gynecol. Surv. 2010, 65, 462–473. [Google Scholar] [CrossRef]
- Isik, G.; Demirezen, S.; Donmez, H.G.; Beksac, M.S. Bacterial vaginosis in association with spontaneous abortion and recurrent pregnancy losses. J. Cytol. 2016, 33, 135–140. [Google Scholar] [CrossRef]
- Donders, G.G. Abnormal vaginal flora in the first trimester, but not full-blown bacterial vaginosis, is associated with preterm birth. Prenat. Neonat. Med. 1998, 3, 588–593. [Google Scholar]
- Mulu, W.; Yimer, M.; Zenebe, Y.; Abera, B. Common causes of vaginal infections and antibiotic susceptibility of aerobic bacterial isolates in women of reproductive age attending at Felegehiwot Referral Hospital, Ethiopia: A cross sectional study. BMC Women’s Health 2015, 15, 42. [Google Scholar] [CrossRef] [PubMed]
- Fan, A.; Yue, Y.; Geng, N.; Zhang, H.; Wang, Y.; Xue, F. Aerobic vaginitis and mixed infections: Comparison of clinical and laboratory findings. Arch. Gynecol. Obstet. 2013, 287, 329–335. [Google Scholar] [CrossRef] [PubMed]
- Donders, G.G.G.; Bellen, G.; Grinceviciene, S.; Ruban, K.; Vieira-Baptista, P. Aerobic vaginitis: No longer a stranger. Res. Microbiol. 2017, 168, 845–858. [Google Scholar] [CrossRef] [PubMed]
- Oerlemans, E.F.M.; Wuyts, S.; Bellen, G.; Wittouck, S.; de Boeck, I.; Ruban, K.; Allonsius, C.N.; van den Broek, M.F.L.; Donders, G.G.G.; Lebeer, S. The Dwindling Microbiota of Aerobic Vaginitis, an Inflammatory State Enriched in Pathobionts with Limited TLR Stimulation. Diagnostics 2020, 10, 879. [Google Scholar] [CrossRef]
- Donders, G.; Bellen, G.; Rezeberga, D. Aerobic vaginitis in pregnancy. BJOG 2011, 118, 1163–1170. [Google Scholar] [CrossRef]
- Donders, G.G. Definition and classification of abnormal vaginal flora. Best. Pract. Res. Clin. Obstet. Gynaecol. 2007, 21, 355–373. [Google Scholar] [CrossRef]
- Donders, G.G.; Vereecken, A.; Bosmans, E.; Dekeersmaecker, A.; Salembier, G.; Spitz, B. Definition of a type of abnormal vaginal flora that is distinct from bacterial vaginosis: Aerobic vaginitis. BJOG 2002, 109, 34–43. [Google Scholar] [CrossRef]
- Fox, C.; Eichelberger, K. Maternal microbiome and pregnancy outcomes. Fertil. Steril. 2015, 104, 1358–1363. [Google Scholar] [CrossRef]
- Nelson, D.B.; Rockwell, L.C.; Prioleau, M.D.; Goetzl, L. The role of the bacterial microbiota on reproductive and pregnancy health. Anaerobe 2016, 42, 67–73. [Google Scholar] [CrossRef]
- Fan, T.; Zhong, X.M.; Wei, X.C.; Miao, Z.L.; Luo, S.Y.; Cheng, H.; Xiao, Q. The alteration and potential relationship of vaginal microbiota and chemokines for unexplained recurrent spontaneous abortion. Medicine 2020, 99, e23558. [Google Scholar] [CrossRef]
- Jiao, X.; Zhang, L.; Du, D.; Wang, L.; Song, Q.; Liu, S. Alteration of vaginal microbiota in patients with recurrent miscarriage. J. Obstet. Gynaecol. 2022, 42, 248–255. [Google Scholar] [CrossRef] [PubMed]
- Donders, G.G.; van Calsteren, K.; Bellen, G.; Reybrouck, R.; van den Bosch, T.; Riphagen, I.; van Lierde, S. Predictive value for preterm birth of abnormal vaginal flora, bacterial vaginosis and aerobic vaginitis during the first trimester of pregnancy. BJOG 2009, 116, 1315–1324. [Google Scholar] [CrossRef] [PubMed]
- Findri-Guštek, Š.; Petek, M.J.; Sarajlija, H.; Mršić, G.; Džepina, A.M.; Oreščanin, V. The correlation of the lifestyle and medical conditions with the vaginal infections and production of 2-phenylethanol. Arch. Gynecol. Obstet. 2012, 286, 671–682. [Google Scholar] [CrossRef] [PubMed]
- Giakoumelou, S.; Wheelhouse, N.; Cuschieri, K.; Entrican, G.; Howie, S.E.; Horne, A.W. The role of infection in miscarriage. Hum. Reprod. Update 2016, 22, 116–133. [Google Scholar] [CrossRef]
- Donders, G.G.; van Bulck, B.; Caudron, J.; Londers, L.; Vereecken, A.; Spitz, B. Relationship of bacterial vaginosis and mycoplasmas to the risk of spontaneous abortion. Am. J. Obstet. Gynecol. 2000, 183, 431–437. [Google Scholar] [CrossRef] [PubMed]
- Hay, P.E. Bacterial vaginosis and miscarriage. Curr. Opin. Infect. Dis. 2004, 17, 41–44. [Google Scholar] [CrossRef]
- Tempera, G.; Furneri, P.M. Management of aerobic vaginitis. Gynecol. Obstet. Investig. 2010, 70, 244–249. [Google Scholar] [CrossRef]
- Verhelst, R.; Verstraelen, H.; Claeys, G.; Verschraegen, G.; van Simaey, L.; de Ganck, C.; de Backer, E.; Temmerman, M.; Vaneechoutte, M. Comparison between Gram stain and culture for the characterization of vaginal microflora: Definition of a distinct grade that resembles grade I microflora and revised categorization of grade I microflora. BMC Microbiol. 2005, 5, 61. [Google Scholar] [CrossRef]
- Dong, M.; Wang, C.; Li, H.; Yan, Y.; Ma, X.; Li, H.; Li, X.; Wang, H.; Zhang, Y.; Qi, W.; et al. Aerobic Vaginitis Diagnosis Criteria Combining Gram Stain with Clinical Features: An Establishment and Prospective Validation Study. Diagnostics 2022, 12, 185. [Google Scholar] [CrossRef]
- Han, C.; Wu, W.; Fan, A.; Wang, Y.; Zhang, H.; Chu, Z.; Wang, C.; Xue, F. Diagnostic and therapeutic advancements for aerobic vaginitis. Arch. Gynecol. Obstet. 2015, 291, 251–257. [Google Scholar] [CrossRef]
- Rumyantseva, T.A.; Bellen, G.; Savochkina, Y.A.; Guschin, A.E.; Donders, G.G. Diagnosis of aerobic vaginitis by quantitative real-time PCR. Arch. Gynecol. Obstet. 2016, 294, 109–114. [Google Scholar] [CrossRef] [PubMed]
- Srinivasan, S.; Fredricks, D.N. The human vaginal bacterial biota and bacterial vaginosis. Interdiscip. Perspect. Infect. Dis. 2008, 2008, 750479. [Google Scholar] [CrossRef] [PubMed]
- National Library of Medicine, National Center for Biotechnology Information. Available online: https://www.ncbi.nlm.nih.gov/ (accessed on 1 July 2022).
- Nami, Y.; Haghshenas, B.; Yari Khosroushahi, A. Molecular Identification and Probiotic Potential Characterization of Lactic Acid Bacteria Isolated from Human Vaginal Microbiota. Adv. Pharm. Bull. 2018, 8, 683–695. [Google Scholar] [CrossRef] [PubMed]
- Serretiello, E.; Santella, B.; Folliero, V.; Iervolino, D.; Santoro, E.; Manente, R.; Dell’Annunziata, F.; Sperlongano, R.; Crudele, V.; de Filippis, A.; et al. Prevalence and Antibiotic Resistance Profile of Bacterial Pathogens in Aerobic Vaginitis: A Retrospective Study in Italy. Antibiotics 2021, 10, 1133. [Google Scholar] [CrossRef] [PubMed]
- Kaiser, T.D.L.; Pereira, E.M.; Dos Santos, K.R.N.; Maciel, E.L.N.; Schuenck, R.P.; Nunes, A.P.F. Modification of the Congo red agar method to detect biofilm production by Staphylococcus epidermidis. Diagn. Microbiol. Infect. Dis. 2013, 75, 235–239. [Google Scholar] [CrossRef]
- Stepanović, S.; Vuković, D.; Hola, V.; Bonaventura, G.D.; Djukić, S.; Ćirković, I.; Ruzicka, F. Quantification of biofilm in microtiter plates: Overview of testing conditions and practical recommendations for assessment of biofilm production by staphylococci. APMIS 2007, 115, 891–899. [Google Scholar] [CrossRef]
- Sengupta, M.; Sarkar, S.; SenGupta, M.; Ghosh, S.; Sarkar, R.; Banerjee, P. Biofilm Producing Enterococcus Isolates from Vaginal Microbiota. Antibiotics 2021, 10, 1082. [Google Scholar] [CrossRef]
- Sacerdoti, F.; Scalise, M.L.; Burdet, J.; Amaral, M.M.; Franchi, A.M.; Ibarra, C. Shiga Toxin-Producing Escherichia coli Infections during Pregnancy. Microorganisms 2018, 6, 111. [Google Scholar] [CrossRef]
- Fan, C.; Dai, Y.; Zhang, L.; Rui, C.; Wang, X.; Luan, T.; Fan, Y.; Dong, Z.; Hou, W.; Li, P.; et al. Aerobic Vaginitis Induced by Escherichia coli Infection During Pregnancy Can Result in Adverse Pregnancy Outcomes Through the IL-4/JAK-1/STAT-6 Pathway. Front. Microbiol. 2021, 12, 651426. [Google Scholar] [CrossRef]
- Gondo, F.; da Silva, M.G.; Polettini, J.; Tristao Ada, R.; Peracoli, J.C.; Witkin, S.S.; Rudge, M.V. Vaginal flora alterations and clinical symptoms in low-risk pregnant women. Gynecol. Obstet. Investig. 2011, 71, 158–162. [Google Scholar] [CrossRef]
- Han, C.; Li, H.; Han, L.; Wang, C.; Yan, Y.; Qi, W.; Fan, A.; Wang, Y.; Xue, F. Aerobic vaginitis in late pregnancy and outcomes of pregnancy. Eur. J. Clin. Microbiol. Infect. Dis. 2019, 38, 233–239. [Google Scholar] [CrossRef] [PubMed]
- Ma, X.; Wu, M.; Wang, C.; Li, H.; Fan, A.; Wang, Y.; Han, C.; Xue, F. The pathogenesis of prevalent aerobic bacteria in aerobic vaginitis and adverse pregnancy outcomes: A narrative review. Reprod. Health 2022, 19, 21. [Google Scholar] [CrossRef] [PubMed]
- Al-Memar, M.; Bobdiwala, S.; Fourie, H.; Mannino, R.; Lee, Y.S.; Smith, A.; Marchesi, J.R.; Timmerman, D.; Bourne, T.; Bennett, P.R.; et al. The association between vaginal bacterial composition and miscarriage: A nested case-control study. BJOG 2020, 127, 264–274. [Google Scholar] [CrossRef] [PubMed]
- Moreno, I.; Garcia-Grau, I.; Bau, D.; Perez-Villaroya, D.; Gonzalez-Monfort, M.; Vilella, F.; Romero, R.; Simon, C. The first glimpse of the endometrial microbiota in early pregnancy. Am. J. Obstet. Gynecol. 2020, 222, 296–305. [Google Scholar] [CrossRef]
- Xu, L.; Huang, L.; Lian, C.; Xue, H.; Lu, Y.; Chen, X.; Xia, Y. Vaginal Microbiota Diversity of Patients with Embryonic Miscarriage by Using 16S rDNA High-Throughput Sequencing. Int. J. Genom. 2020, 2020, 1764959. [Google Scholar] [CrossRef] [PubMed]
- Zhang, F.; Zhang, T.; Ma, Y.; Huang, Z.; He, Y.; Pan, H.; Fang, M.; Ding, H. Alteration of vaginal microbiota in patients with unexplained recurrent miscarriage. Exp. Ther. Med. 2019, 17, 3307–3316. [Google Scholar] [CrossRef]
- Donders, G.G.; Gonzaga, A.; Marconi, C.; Donders, F.; Michiels, T.; Eggermont, N.; Bellen, G.; Lule, J.; Byamughisa, J. Increased vaginal pH in Ugandan women: What does it indicate? Eur. J. Clin. Microbiol. Infect. Dis. 2016, 35, 1297–1303. [Google Scholar] [CrossRef][Green Version]
- Dermendjiev, T.; Pehlivanov, B.; Hadjieva, K.; Stanev, S. Epidemiological, Clinical and Microbiological Findings in Women with Aerobic Vaginitis. Akush. Ginekol. 2015, 54, 4–8. [Google Scholar]
- Jahic, M.; Mulavdic, M.; Nurkic, J.; Jahic, E.; Nurkic, M. Clinical characteristics of aerobic vaginitis and its association to vaginal candidiasis, trichomonas vaginitis and bacterial vaginosis. Med. Arch. 2013, 67, 428–430. [Google Scholar] [CrossRef]
- Salinas, A.M.; Osorio, V.G.; Pacha-Herrera, D.; Vivanco, J.S.; Trueba, A.F.; Machado, A. Vaginal microbiota evaluation and prevalence of key pathogens in ecuadorian women: An epidemiologic analysis. Sci. Rep. 2020, 10, 18358. [Google Scholar] [CrossRef]
- Cicinelli, E.; Matteo, M.; Tinelli, R.; Pinto, V.; Marinaccio, M.; Indraccolo, U.; de Ziegler, D.; Resta, L. Chronic endometritis due to common bacteria is prevalent in women with recurrent miscarriage as confirmed by improved pregnancy outcome after antibiotic treatment. Reprod. Sci. 2014, 21, 640–647. [Google Scholar] [CrossRef] [PubMed]
- Soyer Caliskan, C.; Yurtcu, N.; Celik, S.; Sezer, O.; Kilic, S.S.; Cetin, A. Derangements of vaginal and cervical canal microbiota determined with real-time PCR in women with recurrent miscarriages. J. Obstet. Gynaecol. 2022, 42, 2105–2114. [Google Scholar] [CrossRef] [PubMed]
- Li, H.; Zang, Y.; Wang, C.; Li, H.; Fan, A.; Han, C.; Xue, F. The Interaction Between Microorganisms, Metabolites, and Immune System in the Female Genital Tract Microenvironment. Front. Cell. Infect. Microbiol. 2020, 10, 609488. [Google Scholar] [CrossRef] [PubMed]
- Najmi, N.; Jehan, I.; Sikandar, R.; Zuberi, N.F. Maternal genital tract colonisation by group-B streptococcus: A hospital based study. J. Pak. Med. Assoc. 2013, 63, 1103–1107. [Google Scholar]
- Kaambo, E.; Africa, C.W.J. The Threat of Aerobic Vaginitis to Pregnancy and Neonatal Morbidity. Afr. J. Reprod. Health 2017, 21, 108–118. [Google Scholar] [CrossRef]
- Munir, A.; Qureshi, A.I.; Rasheed, T.; Shafi, S.; Gul, P.I.; Tahir, U.A. Recurrent Miscarriages in Advance Maternal Age (>35 Years). Pak. J. Med. Health Sci. 2022, 16, 247–247. [Google Scholar] [CrossRef]
- Zheng, D.; Li, C.; Wu, T.; Tang, K. Factors associated with spontaneous abortion: A cross-sectional study of Chinese populations. Reprod. Health 2017, 14, 33. [Google Scholar] [CrossRef]
- Adib-Rad, H.; Basirat, Z.; Faramarzi, M.; Mostafazadeh, A.; Bijani, A. Psychological distress in women with recurrent spontaneous abortion: A case-control study. Turk. J. Obstet. Gynecol. 2019, 16, 151–157. [Google Scholar] [CrossRef]
- Danielsson, D.; Teigen, P.K.; Moi, H. The genital econiche: Focus on microbiota and bacterial vaginosis. Ann. N. Y. Acad. Sci. 2011, 1230, 48–58. [Google Scholar] [CrossRef]
- Sugiura-Ogasawara, M.; Suzuki, S.; Ozaki, Y.; Katano, K.; Suzumori, N.; Kitaori, T. Frequency of recurrent spontaneous abortion and its influence on further marital relationship and illness: The Okazaki Cohort Study in Japan. J. Obstet. Gynaecol. Res. 2013, 39, 126–131. [Google Scholar] [CrossRef]
- Kaambo, E.; Africa, C.; Chambuso, R.; Passmore, J.S. Vaginal Microbiomes Associated with Aerobic Vaginitis and Bacterial Vaginosis. Front. Public Health 2018, 6, 78. [Google Scholar] [CrossRef] [PubMed]
- Borgdorff, H.; van der Veer, C.; van Houdt, R.; Alberts, C.J.; de Vries, H.J.; Bruisten, S.M.; Snijder, M.B.; Prins, M.; Geerlings, S.E.; Schim van der Loeff, M.F.; et al. The association between ethnicity and vaginal microbiota composition in Amsterdam, the Netherlands. PLoS ONE 2017, 12, e0181135. [Google Scholar] [CrossRef] [PubMed]
- Santiago, G.L.; Cools, P.; Verstraelen, H.; Trog, M.; Missine, G.; El Aila, N.; Verhelst, R.; Tency, I.; Claeys, G.; Temmerman, M.; et al. Longitudinal study of the dynamics of vaginal microflora during two consecutive menstrual cycles. PLoS ONE 2011, 6, e28180. [Google Scholar] [CrossRef]
- Vaneechoutte, M. The human vaginal microbial community. Res. Microbiol. 2017, 168, 811–825. [Google Scholar] [CrossRef] [PubMed]
- Zhou, C.; Fey, P.D. The acid response network of Staphylococcus aureus. Curr. Opin. Microbiol. 2020, 55, 67–73. [Google Scholar] [CrossRef]
- Tomas, M.; Palmeira-de-Oliveira, A.; Simoes, S.; Martinez-de-Oliveira, J.; Palmeira-de-Oliveira, R. Bacterial vaginosis: Standard treatments and alternative strategies. Int. J. Pharm. 2020, 587, 119659. [Google Scholar] [CrossRef]
- Yasin, J.; Ayalew, G.; Dagnaw, M.; Shiferaw, G.; Mekonnen, F.J.I.; Resistance, D. Vulvovaginitis prevalence among women in gondar, Northwest Ethiopia: Special emphasis on aerobic vaginitis causing bacterial profile, antimicrobial susceptibility pattern, and associated factors. Infect. Drug Resist. 2021, 14, 4567. [Google Scholar] [CrossRef]
- Farinati, A.; Semeshchenko, D.; Santalucía, M.; Marqués, M.; Orsini, A. Endocervical biofilms in women with endogenous infections in the lower genital tract: In vitro study. Braz. J. Sex. Transm. Dis. 2013, 25, 190–195. [Google Scholar]
- Wang, C.; Fan, A.; Li, H.; Yan, Y.; Qi, W.; Wang, Y.; Han, C.; Xue, F. Vaginal bacterial profiles of aerobic vaginitis: A case-control study. Diagn. Microbiol. Infect. Dis. 2020, 96, 114981. [Google Scholar] [CrossRef]
- Donders, G.G.; Ruban, K.; Bellen, G. Selecting anti-microbial treatment of aerobic vaginitis. Curr. Infect. Dis. Rep. 2015, 17, 477. [Google Scholar] [CrossRef]
- Tempera, G.; Bonfiglio, G.; Cammarata, E.; Corsello, S.; Cianci, A. Microbiological/clinical characteristics and validation of topical therapy with kanamycin in aerobic vaginitis: A pilot study. Int. J. Antimicrob. Agents 2004, 24, 85–88. [Google Scholar] [CrossRef] [PubMed]
- Boccella, M.; Santella, B.; Pagliano, P.; de Filippis, A.; Casolaro, V.; Galdiero, M.; Borrelli, A.; Capunzo, M.; Boccia, G.; Franci, G. Prevalence and Antimicrobial Resistance of Enterococcus Species: A Retrospective Cohort Study in Italy. Antibiotics 2021, 10, 1552. [Google Scholar] [CrossRef] [PubMed]
- Tacconelli, E.; Carrara, E.; Savoldi, A.; Harbarth, S.; Mendelson, M.; Monnet, D.L.; Pulcini, C.; Kahlmeter, G.; Kluytmans, J.; Carmeli, Y.; et al. Discovery, research, and development of new antibiotics: The WHO priority list of antibiotic-resistant bacteria and tuberculosis. Lancet. Infect. Dis. 2018, 18, 318–327. [Google Scholar] [CrossRef]
- Donders, G.; Bellen, G.; Neven, P.; Grob, P.; Prasauskas, V.; Buchholz, S.; Ortmann, O. Effect of ultra-low-dose estriol and lactobacilli vaginal tablets (Gynoflor®) on inflammatory and infectious markers of the vaginal ecosystem in postmenopausal women with breast cancer on aromatase inhibitors. Eur. J. Clin. Microbiol. Infect. Dis. 2015, 34, 2023–2028. [Google Scholar] [CrossRef] [PubMed]
- Li, J.; McCormick, J.; Bocking, A.; Reid, G. Importance of vaginal microbes in reproductive health. Reprod. Sci. 2012, 19, 235–242. [Google Scholar] [CrossRef]
- Sonthalia, S.; Aggarwal, P.; Das, S.; Sharma, P.; Sharma, R.; Singh, S. Aerobic vaginitis—An underdiagnosed cause of vaginal discharge—Narrative review. Int. J. STD AIDS 2020, 31, 1018–1027. [Google Scholar] [CrossRef]
- Stojanović, N.; Plećaš, D.; Plešinac, S. Normal vaginal flora, disorders and application of probiotics in pregnancy. Arch. Gynecol. Obstet. 2012, 286, 325–332. [Google Scholar] [CrossRef]
- Lindsay, K.L.; Walsh, C.A.; Brennan, L.; McAuliffe, F.M. Probiotics in pregnancy and maternal outcomes: A systematic review. J. Matern. Neonatal Med. 2013, 26, 772–778. [Google Scholar] [CrossRef]
- Gille, C.; Böer, B.; Marschal, M.; Urschitz, M.S.; Heinecke, V.; Hund, V.; Speidel, S.; Tarnow, I.; Mylonas, I.; Franz, A.; et al. Effect of probiotics on vaginal health in pregnancy. EFFPRO, a randomized controlled trial. Am. J. Obstet. Gynecol. 2016, 215, 608.e1–608.e7. [Google Scholar] [CrossRef]
- Griffin, C. Probiotics in obstetrics and gynaecology. Aust. N. Z. J. Obstet. Gynaecol. 2015, 55, 201–209. [Google Scholar] [CrossRef]
- Jeng, H.S.; Yan, T.R.; Chen, J.Y. Treating vaginitis with probiotics in non-pregnant females: A systematic review and meta-analysis. Exp. Ther. Med. 2020, 20, 3749–3765. [Google Scholar] [CrossRef] [PubMed]
- Borges, S.; Silva, J.; Teixeira, P. The role of lactobacilli and probiotics in maintaining vaginal health. Arch. Gynecol. Obstet. 2014, 289, 479–489. [Google Scholar] [CrossRef] [PubMed]
- Boris, S.; Barbés, C. Role played by lactobacilli in controlling the population of vaginal pathogens. Microbes Infect. 2000, 2, 543–546. [Google Scholar] [CrossRef]
- Dehpahni, M.F.; Chehri, K.; Azadbakht, M. Therapeutic effects of silver nanoparticle and L-carnitine on aerobic vaginitis in mice: An experimental study. Bioimpacts 2022, 12, 33. [Google Scholar] [CrossRef] [PubMed]
- Cirkovic, I.; Bozic, D.D.; Draganic, V.; Lozo, J.; Beric, T.; Kojic, M.; Arsic, B.; Garalejic, E.; Djukic, S.; Stankovic, S. Licheniocin 50.2 and bacteriocins from Lactococcus lactis subsp. lactis biovar. diacetylactis BGBU1-4 inhibit biofilms of coagulase negative Staphylococci and Listeria monocytogenes clinical isolates. PLoS ONE 2016, 11, e0167995. [Google Scholar]
- Gaspar, C.; Donders, G.; Palmeira-de-Oliveira, R.; Queiroz, J.; Tomaz, C.; Martinez-de-Oliveira, J.; Palmeira-de-Oliveira, A. Bacteriocin production of the probiotic Lactobacillus acidophilus KS400. AMB Express 2018, 8, 1–8. [Google Scholar] [CrossRef]
- Tytgat, H.L.; Douillard, F.P.; Reunanen, J.; Rasinkangas, P.; Hendrickx, A.P.; Laine, P.K.; Paulin, L.; Satokari, R.; de Vos, W.M. Lactobacillus rhamnosus GG outcompetes Enterococcus faecium via mucus-binding pili: Evidence for a novel and heterospecific probiotic mechanism. Appl. Environ. Microbiol. 2016, 82, 5756–5762. [Google Scholar] [CrossRef]

| Score | LBG (1000×) | No of Leucocytes/Epithelial Cells (400×) | Background Flora (1000×) | Proportion of PBC (400×) | Clinical Symptoms |
|---|---|---|---|---|---|
| 0 | I,IIa | ≤10 | No other bacteria | <1% | pH ≤ 4.5 and no abnormal symptoms |
| 1 | IIb | ≤10 | Small bacilli | ≥1% and ≤10% | pH > 4.5 or at least one abnormal symptom |
| 2 | III | >10 | Cocci or chains | >10% | pH > 4.5 and at least one abnormal symptom |
| Clinical Features | RPL Group | Control Group | p-Value |
|---|---|---|---|
| N = 115 | N = 65 | N = 50 | t-Test |
| Average (min-max) | |||
| Woman’s age (years) | 35.54 (20–48) | 34.26 (25–42) | n.s |
| Body mass index (BMI) kg/m2 | 26.49 (17.19–33.79) | 26.77 (19.47–34.63) | n.s |
| Gravidity | 3.51 (2–7) | 3.18 (2–5) | n.s |
| Parity | 0.08 (0–1) | 3.18 (2–5) | <0.0001 * |
| Vaginal Ph | 4.88 (3.8–6.3) | 4.24 (3.8–4.9) | <0.0001 * |
| Number (%) | p-value X2 | ||
| Level of education | <0.0001 * | ||
| No education | 18 (27.7%) | 4 (8.0%) | |
| Intermediate | 40 (61.5%) | 23 (46.0%) | |
| Higher | 7 (10.8%) | 23 (46.0%) | |
| Smoking | n.s | ||
| Yes | 6 (9.2) | 7 (14.0%) | |
| No | 59 (90.8%) | 43 (86.0%) | |
| Residence | <0.0001 * | ||
| Urban | 24 (36.9%) | 38 (76.0%) | |
| Rural | 41 (63.1%) | 12 (24.0%) | |
| Blood groups | n.s | ||
| A | 17 (26.2%) | 16 (32.0%) | |
| B | 8 (12.3%) | 3 (6.0%) | |
| O | 40 (61.5%) | 31 (62.0%) | |
| Menstrual cycle | <0.0001 * | ||
| Regular | 8 (12.3%) | 40 (80.0%) | |
| Irregular | 57 (87.7%) | 10 (20.0%) | |
| Aerobic vaginitis (AV) ** | <0.0001 * | ||
| No AV | 19 (29.23%) | 44 (88%) | |
| Mild AV | 11 (16.92%) | 5 (10%) | |
| Moderate | 21 (32.30%) | 1 (2%) | |
| Severe | 10 (15.38%) | 0 | |
| Bacterial vaginosis | 2 (3.07%) | 0 | n.s |
| Candidosis | 2 (3.07%) | 0 | n.s |
| Variable | Odds Ratio [OR] | 95% Confidence Interval | Statistical Significance |
|---|---|---|---|
| Menstrual irregularity | 29.88 | 9.73–91.73 | <0.0001 * |
| Aerobic vaginitis | 7.34 | 1.99–27.01 | p < 0.05 * |
| Rural area | 0.171 | 0.05–0.53 | p < 0.05 * |
| Education level | 0.226 | 0.04–1.05 | n.s |
| Strain | Accession Number |
|---|---|
| MZ474967 |
| MZ474968 |
| MZ474972 |
| MZ474973 |
| MZ474974 |
| MZ474975 |
| MZ474980 |
| MZ474984 |
| MZ474990 |
| MZ474993 |
| MZ474994 |
| MZ474997 |
| MZ475000 |
| MZ475001 |
| MZ475004 |
| MZ475005 |
| MZ475007 |
| MZ475012 |
| MZ475013 |
| MZ475017 |
| MZ474978 |
| MZ474985 |
| MZ474986 |
| MZ474988 |
| MZ474991 |
| MZ474995 |
| MZ474969 |
| MZ474977 |
| MZ474983 |
| MZ474989 |
| MZ474996 |
| MZ475002 |
| MZ475003 |
| MZ475011 |
| MZ475010 |
| MZ475016 |
| MZ474976 |
| MZ474971 |
| MZ474998 |
| MZ474982 |
| MZ474979 |
| MZ475014 |
| MZ474970 |
| MZ475015 |
| MZ474992 |
| MZ475008 |
| MZ475009 |
| MZ474999 |
| MZ474987 |
| MZ475006 |
| Species * (n) | E. faecalis (20/44) | E. faecium (6/44) | S. haemolyticus (8/44) | S. aureus (2/44) | S. caprae (1/44) | S. hominis (1/44) | S. epidermidis (1/44) | Stp. pasteurians (1/44) | Stp. mitis (1/44) | Stp. spp. (1/44) | E. coli (1/44) | Klebsiella spp. (1/44) | Total Resistance n (%) |
|---|---|---|---|---|---|---|---|---|---|---|---|---|---|
| OXA (1 µg) | - | - | 2 R | 2 R | S | R | R | - | - | - | - | - | 6 (46.15%) |
| PG (1 µg) | - | - | - | 1 R | - | - | - | S | R | R | - | - | 3 (60%) |
| AMP (2 µg) | 7 R | 4 R | - | - | - | - | - | - | - | - | R (10 µg) | R (10 µg) | 13 (46.42%) |
| GEN (10 µg) | - | - | 5 R | 2 R | S | R | R | - | - | - | R | 1 | 11 (73.33%) |
| GEN HL (30 µg) | 9 R | 4 R | - | - | - | - | - | R (500 µg) | S (500 µg) | R (500 µg) | - | - | 15 (51.72%) |
| STR HL (300 µg) | 12 R | 6 R | - | - | - | - | - | R | R | R | - | - | 21 (72.41%) |
| KAN (30 µg) | 15 R | 3 R | 4 R | 2 R | S | S | S | R | R | R | S | S | 27 (61.36%) |
| ERY (15 μg) | 17 R | 5 R | 6 R | 1 R | R | R | R | R | R | - | - | 35 (83.33%) | |
| CLI (2 µg) | - | - | 6 R | 2 R | S | S | S | R | S | S | - | - | 9 (56.25%) |
| VAN (5 µg) | 19 R | 3 R | 2 R | 1 R | S | S | S | S | S | S | - | - | 25 (59.52%) |
| TET (30 µg) | 14 R | 6 R | 4 R | 1 R | R | R | R | R | R | R | - | - | 31 (73.80%) |
| CIP (5 µg) | - | - | 5 R | 2 R | S | R | R | R | S | S | R | R | 12 (66.66%) |
Publisher’s Note: MDPI stays neutral with regard to jurisdictional claims in published maps and institutional affiliations. |
© 2022 by the authors. Licensee MDPI, Basel, Switzerland. This article is an open access article distributed under the terms and conditions of the Creative Commons Attribution (CC BY) license (https://creativecommons.org/licenses/by/4.0/).
Share and Cite
Ncib, K.; Bahia, W.; Leban, N.; Mahdhi, A.; Trifa, F.; Mzoughi, R.; Haddad, A.; Jabeur, C.; Donders, G. Microbial Diversity and Pathogenic Properties of Microbiota Associated with Aerobic Vaginitis in Women with Recurrent Pregnancy Loss. Diagnostics 2022, 12, 2444. https://doi.org/10.3390/diagnostics12102444
Ncib K, Bahia W, Leban N, Mahdhi A, Trifa F, Mzoughi R, Haddad A, Jabeur C, Donders G. Microbial Diversity and Pathogenic Properties of Microbiota Associated with Aerobic Vaginitis in Women with Recurrent Pregnancy Loss. Diagnostics. 2022; 12(10):2444. https://doi.org/10.3390/diagnostics12102444
Chicago/Turabian StyleNcib, Karima, Wael Bahia, Nadia Leban, Abdelkarim Mahdhi, Fatma Trifa, Ridha Mzoughi, Anis Haddad, Chédia Jabeur, and Gilbert Donders. 2022. "Microbial Diversity and Pathogenic Properties of Microbiota Associated with Aerobic Vaginitis in Women with Recurrent Pregnancy Loss" Diagnostics 12, no. 10: 2444. https://doi.org/10.3390/diagnostics12102444
APA StyleNcib, K., Bahia, W., Leban, N., Mahdhi, A., Trifa, F., Mzoughi, R., Haddad, A., Jabeur, C., & Donders, G. (2022). Microbial Diversity and Pathogenic Properties of Microbiota Associated with Aerobic Vaginitis in Women with Recurrent Pregnancy Loss. Diagnostics, 12(10), 2444. https://doi.org/10.3390/diagnostics12102444

